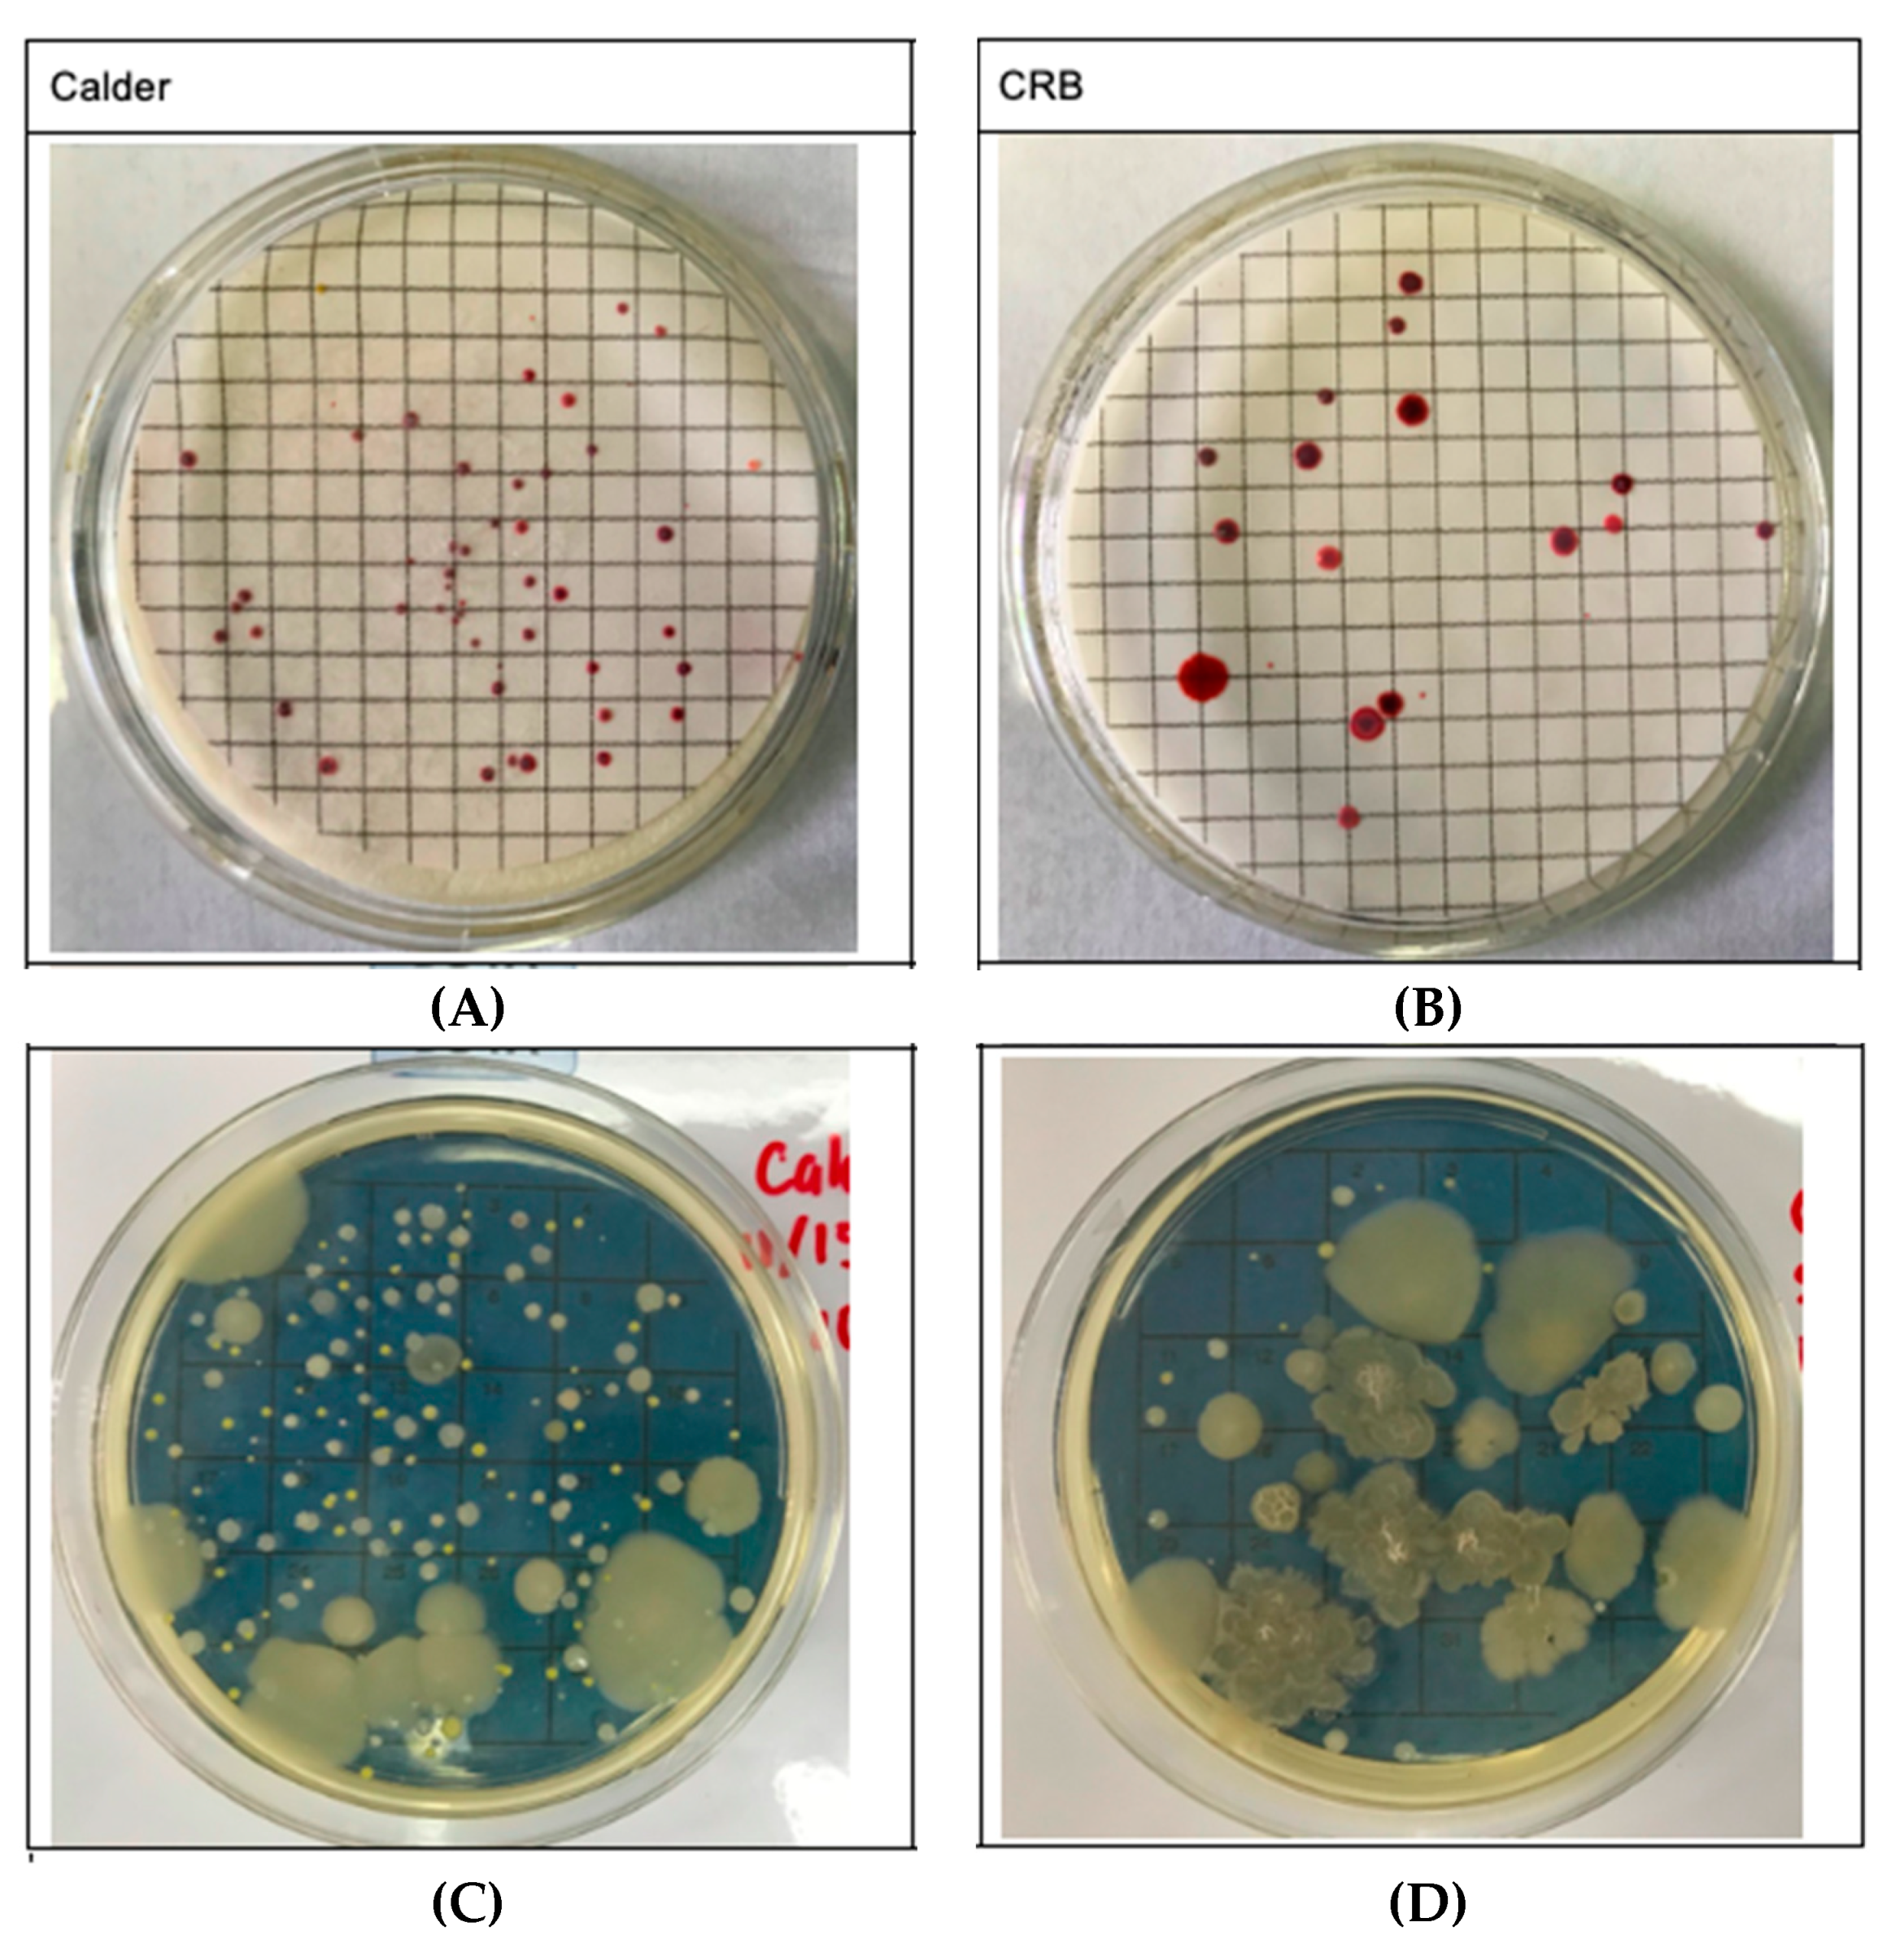

Relationships Between Short-Term Exposure to an Indoor Environment and Dry Eye (DE) Symptoms
Abstract
1. Introduction
2. Materials and Methods
2.1. Study Design
2.2. Environmental Monitoring
2.3. Statistical Analysis
3. Results
3.1. Study Population
3.2. Indoor Air Quality
3.3. Dry Eye Symptoms
3.4. Time in Building and its Impact on DE Symptoms
4. Discussion
Author Contributions
Funding
Conflicts of Interest
References
- Craig, J.P.; Nichols, K.K.; Akpek, E.K.; Caffery, B.; Dua, H.S.; Joo, C.K.; Liu, Z.; Nelson, J.D.; Nichols, J.J.; Tsubota, K.; et al. TFOS DEWS II Definition and Classification Report. Ocul. Surf. 2017, 15. [Google Scholar] [CrossRef] [PubMed]
- Stapleton, F.; Alves, M.; Bunya, V.Y.; Jalbert, I.; Lekhanont, K.; Malet, F.; Na, K.S.; Schaumberg, D.; Uchino, M.; Vehof, J.; et al. TFOS DEWS II Epidemiology Report. Ocul. Surf. 2017, 15, 334–365. [Google Scholar] [CrossRef] [PubMed]
- Yu, J.; Asche, C.V.; Fairchild, C.J. The economic burden of dry eye disease in the United States: A decision tree analysis. Cornea 2011, 30, 379–387. [Google Scholar] [CrossRef] [PubMed]
- Galor, A.; Kumar, N.; Feuer, W.; Lee, D.J. Environmental Factors Affect the Risk of Dry Eye Syndrome in a United States Veteran Population. Ophthalmology 2014, 121, 972–973. [Google Scholar] [CrossRef] [PubMed]
- Wolkoff, P. Ocular discomfort by environmental and personal risk factors altering the precorneal tear film. Toxicol. Lett. 2010, 199, 203–212. [Google Scholar] [CrossRef] [PubMed]
- Mo, Z.; Fu, Q.; Lyu, D.; Zhang, L.; Qin, Z.; Tang, Q.; Yin, H.; Xu, P.; Wu, L.; Wang, X.; et al. Impacts of air pollution on dry eye disease among residents in Hangzhou, China: A case-crossover study. Environ. Pollut. 2019, 246, 183–189. [Google Scholar] [CrossRef]
- Novaes, P.; Saldiva, P.H.; Matsuda, M.; Macchione, M.; Rangel, M.P.; Kara-José, N.; Berra, A. The effects of chronic exposure to traffic derived air pollution on the ocular surface. Environ. Res. 2010, 110, 372–374. [Google Scholar] [CrossRef]
- Agle, E.; Galbraith, S. Building Air Quality—A Guide for Building Owners and Facility Managers; The US Environmental Protection Agency, Center for Disease Control and the National Institute for Occupational Safety and Health (NIOSH): Washington, DC, USA, 1991.
- EPA. Introduction to Indoor Air Quality; US Environmental Protection Agency: Washington, DC, USA, 2020.
- Claeson, A.-S.; Andersson, H.; Wikdahl, F.; Nyback, M.-H.; Nordin, S. Comorbidity of Airway Inflammatory Diseases in Chemical and Building-Related Intolerance. J. Occup. Environ. Med. 2018, 60, 295–300. [Google Scholar] [CrossRef]
- Norbäck, D.; Hashim, J.H.; Cai, G.H.; Hashim, Z.; Ali, F.; Bloom, E.; Larsson, L. Rhinitis, Ocular, Throat and Dermal Symptoms, Headache and Tiredness among Students in Schools from Johor Bahru, Malaysia: Associations with Fungal DNA and Mycotoxins in Classroom Dust. PLoS ONE 2016, 11, e0147996. [Google Scholar] [CrossRef]
- Pitarma, R.; Marques, G.; Ferreira, B.R. Monitoring Indoor Air Quality for Enhanced Occupational Health. J. Med. Syst. 2016, 41, 23. [Google Scholar] [CrossRef]
- Lukcso, D.; Guidotti, T.L.; Franklin, D.E.; Burt, A. Indoor environmental and air quality characteristics, building-related health symptoms, and worker productivity in a federal government building complex. Arch. Environ. Occup. Health 2016, 71, 85–101. [Google Scholar] [CrossRef] [PubMed]
- Maoz-Segal, R.; Agmon-Levin, N.; Israeli, E.; Shoenfeld, Y. The sick building syndrome as a part of ‘ASIA’ (autoimmune/auto-inflammatory syndrome induced by adjuvants). Harefuah 2015, 154, 129–132. [Google Scholar] [PubMed]
- Nordström, K.; Norbäck, D.; Akselsson, R. Influence of indoor air quality and personal factors on the sick building syndrome (SBS) in Swedish geriatric hospitals. Occup. Environ. Med. 1995, 52, 170–176. [Google Scholar] [CrossRef] [PubMed]
- de Magalhães Rios, J.L.; Boechat, J.L.; Gioda, A.; dos Santos, C.Y.; de Aquino Neto, F.R.; de Silva, J.R.L. Symptoms prevalence among office workers of a sealed versus a non-sealed building: Associations to indoor air quality. Environ. Int. 2009, 35, 1136–1141. [Google Scholar] [CrossRef]
- Wakayama, T.; Ito, Y.; Sakai, K.; Miyake, M.; Shibata, E.; Ohno, H.; Kamijima, M. Comprehensive review of 2-ethyl-1-hexanol as an indoor air pollutant. J. Occup. Health 2019, 61, 19–35. [Google Scholar] [CrossRef] [PubMed]
- Wolkoff, P.; Wilkins, C.; Clausen, P.; Nielsen, G. Organic Compounds in Office Environments—Sensory Irritation, Odor, Measurements and the Role of Reactive Chemistry. Indoor Air 2006, 16, 7–19. [Google Scholar] [CrossRef]
- Backman, H.; Haghighat, F. Indoor-air quality and ocular discomfort. J. Am. Optom. Assoc. 1999, 70, 309–316. [Google Scholar]
- Dally, K.A.; Hanrahan, L.P.; Woodbury, M.A.; Kanarek, M.S. Formaldehyde exposure in nonoccupational environments. Arch. Environ. Health 1981, 36, 277–284. [Google Scholar] [CrossRef]
- Bakke, J.V.; Wieslander, G.; Norbäck, D.; Moen, B.E. Atopy, symptoms and indoor environmental perceptions, tear film stability, nasal patency and lavage biomarkers in university staff. Int. Arch. Occup. Environ. Health 2008, 81, 861–872. [Google Scholar] [CrossRef]
- Pan, Z.; Molhave, L.; Kjaergaard, S.K. Effects on Eyes and Nose in Humans after Experimental Exposure to Airborne Office Dust. Indoor Air 2000, 10, 237–245. [Google Scholar] [CrossRef]
- Lu, C.-Y.; Lin, J.-M.; Chen, Y.-Y.; Chen, Y.-C. Building-Related Symptoms among Office Employees Associated with Indoor Carbon Dioxide and Total Volatile Organic Compounds. Int. J. Environ. Res. Public Health 2015, 12, 5833–5845. [Google Scholar] [CrossRef] [PubMed]
- EPA. The Total Exposure Assessment Methodology (TEAM) Study: Summary and Analysis; Agency UDoEP, Ed.; EPA: Washington, DC, USA, 1987.
- US-EPA. Report to Congress on Indoor Air Quality: Volume 2; EPA/400/1-89/001C; US-EPA: Washington, DC, USA, 1989.
- Samet, J.; Buist, S.; Bascom, R.; Garcia, J.; Lipsett, M.; Mauderly, J.; Mannino, D.; Ran, C.; Romieu, I.; Utell, M.; et al. What Constitutes an Adverse Health Effect of Air Pollution? Am. J. Respir. Crit. Care Med. 2000, 161, 665–673. [Google Scholar] [CrossRef]
- StataCorp. Stata Statistical Software: Release 14; StataCorp LP: College Station, TX, USA, 2015. [Google Scholar]
- Fanger, P.O. Indoor Air Quality in the 21st Century: Search for Excellence. Indoor Air 2000, 10, 68–73. [Google Scholar] [CrossRef]
- Franck, C.; Bach, E.; Skov, P. Prevalence of objective eye manifestations in people working in office buildings with different prevalences of the sick building syndrome compared with the general population. Int. Arch. Occup. Environ. Health 1993, 65. [Google Scholar] [CrossRef] [PubMed]
- Kim, Y.; Paik, H.J.; Kim, M.K.; Choi, Y.-H.; Kim, D.H. Short-Term Effects of Ground-Level Ozone in Patients With Dry Eye Disease: A Prospective Clinical Study. Cornea 2019, 38, 1483–1488. [Google Scholar] [CrossRef] [PubMed]
- Zhong, J.-Y.; Lee, Y.-C.; Hsieh, C.-J.; Tseng, C.-C.; Yiin, L.-M. Association between Dry Eye Disease, Air Pollution and Weather Changes in Taiwan. Int. J. Environ. Res. Public Health 2018, 15, 2269. [Google Scholar] [CrossRef]
- Lundholm, M.; Lavrell, G.; Mathiasson, L. Self-Leveling Mortar as a Possible Cause of Symptoms Associated with “Sick Building Syndrome”. Arch. Environ. Health 2009, 45, 135–140. [Google Scholar] [CrossRef]
- Letz, G.A. Sick building syndrome: Acute illness among office workers—The role of building ventilation, airborne contaminants and work stress. Allergy Proc. 1990, 11, 109–116. [Google Scholar] [CrossRef]
- Yang, Q.; Li, K.; Li, D.; Zhang, Y.; Liu, X.; Wu, K. Effects of fine particulate matter on the ocular surface: An in vitro and in vivo study. Biomed. Pharmacother. 2019, 117, 109177. [Google Scholar] [CrossRef]
- Tan, G.; Li, J.; Yang, Q.; Wu, A.; Qu, D.Y.; Wang, Y.; Ye, L.; Bao, J.; Shao, Y. Air pollutant particulate matter 2.5 induces dry eye syndrome in mice. Sci. Rep. 2018, 8, 17828. [Google Scholar] [CrossRef]
- Li, J.; Tan, G.; Ding, X.; Wang, Y.; Wu, A.; Yang, Q.; Ye, L.; Shao, Y. A mouse dry eye model induced by topical administration of the air pollutant particulate matter 10. Biomed. Pharmacother. 2017, 96, 524–534. [Google Scholar] [CrossRef] [PubMed]
- Wolkoff, P. Indoor air humidity, air quality, and health—An overview. Int. J. Hyg. Environ. Health 2018, 221, 376–390. [Google Scholar] [CrossRef] [PubMed]
- Wolkoff, P.; Kjaergaard, S. The dichotomy of relative humidity on indoor air quality. Environ. Int. 2007, 33, 850–857. [Google Scholar] [CrossRef] [PubMed]
- Azuma, K.; Ikeda, K.; Kagi, N.; Yanagi, U.; Osawa, H. Evaluating prevalence and risk factors of building-related symptoms among office workers: Seasonal characteristics of symptoms and psychosocial and physical environmental factors. Environ. Health Prev. Med. 2017, 22, 38. [Google Scholar] [CrossRef]
- Johanning, E.; Auger, P.; Morey, P.R.; Yang, C.S.; Olmsted, E. Review of health hazards and prevention measures for response and recovery workers and volunteers after natural disasters, flooding, and water damage: Mold and dampness. Environ. Health Prev. Med. 2014, 19, 93–99. [Google Scholar] [CrossRef]
- Yokoi, N.; Uchino, M.; Uchino, Y.; Dogru, M.; Kawashima, M.; Komuro, A.; Sonomura, Y.; Kato, H.; Tsubota, K.; Kinoshita, S. Importance of Tear Film Instability in Dry Eye Disease in Office Workers Using Visual Display Terminals: The Osaka Study. Am. J. Ophthalmol. 2015, 159, 748–754. [Google Scholar] [CrossRef]
- de Kluizenaar, Y.; Roda, C.; Dijkstra, N.E.; Fossati, S.; Mandin, C.; Michucz, V.G.; Hänninen, O.; de Oliveira Fernandes, E.; Silva, G.V.; Carrer, P.; et al. Office characteristics and dry eye complaints in European workers–The OFFICAIR study. Build. Environ. 2016, 102, 54–63. [Google Scholar] [CrossRef]
- Franck, C. Eye symptoms and signs in buildings with indoor climate problems (‘office eye syndrome’). Acta Ophthalmol. 1986, 64, 306–311. [Google Scholar] [CrossRef]
- Galor, A.; Feuer, W.; Lee, D.J.; Florez, H.; Venincasa, V.D.; Perez, V.L. Ocular surface parameters in older male veterans. Investig. Ophthalmol. Vis. Sci. 2013, 54, 1426–1433. [Google Scholar] [CrossRef]
- Karakus, S.; Mathews, P.M.; Agrawal, D.; Henrich, C.; Ramulu, P.Y.; Akpek, E.K. Impact of Dry Eye on Prolonged Reading. Optom. Vis. Sci. 2018, 95, 1105–1111. [Google Scholar] [CrossRef]
- Prabhasawat, P.; Pinitpuwadol, W.; Angsriprasert, D.; Chonpimai, P.; Saiman, M. Tear film change and ocular symptoms after reading printed book and electronic book: A crossover study. Jpn. J. Ophthalmol. 2019, 63, 137–144. [Google Scholar] [CrossRef] [PubMed]
- Wolkoff, P.; Kärcher, T.; Mayer, H. Problems of the “outer eyes” in the office environment: An ergophthalmologic approach. J. Occup. Environ. Med. 2012, 54, 621–631. [Google Scholar] [CrossRef] [PubMed]
- Becher, R.; Øvrevik, J.; Schwarze, P.E.; Nilsen, S.; Hongslo, J.K.; Bakke, J.V. Do Carpets Impair Indoor Air Quality and Cause Adverse Health Outcomes: A Review. Int. J. Environ. Res. Public Health 2018, 15, 184. [Google Scholar] [CrossRef] [PubMed]
- Cincinelli, A.; Martellini, T. Indoor Air Quality and Health. Int. J. Environ. Res. Public Health 2017, 14, 1286. [Google Scholar] [CrossRef] [PubMed]
- Maula, H.; Hongisto, V.; Naatula, V.; Haapakangas, A.; Koskela, H. The effect of low ventilation rate with elevated bioeffluent concentration on work performance, perceived indoor air quality, and health symptoms. Indoor Air 2017, 27, 1141–1153. [Google Scholar] [CrossRef]
- Sundell, J. On the history of indoor air quality and health. Indoor Air 2004, 14 (Suppl. 7), 51–58. [Google Scholar] [CrossRef]
- Mosaddegh, M.; Jafarian, A.; Ghasemi, A.; Mosaddegh, A. Phytoremediation of benzene, toluene, ethylbenzene and xylene contaminated air by D. deremensis and O. microdasys plants. J. Environ. Health Sci. Eng. 2014, 12, 39. [Google Scholar] [CrossRef]
- Kolarik, J.; Wargocki, P. Can a photocatalytic air purifier be used to improve the perceived air quality indoors? Indoor Air 2010, 20, 255–262. [Google Scholar] [CrossRef]
- Hanssen, S. HVAC—The importance of clean intake section and dry air filter in cold climate. Indoor Air 2004, 14 (Suppl. 7), 195–201. [Google Scholar] [CrossRef]
- Lahtinen, M.; Salonen, H.; Lappalainen, S.; Huttunen, J.; Reijula, K. Renovation of a “sick building”: The challenge of attaining the confidence of occupants. Am. J. Ind. Med. 2009, 52, 438–445. [Google Scholar] [CrossRef]
- Zuraimi, M.S. Is ventilation duct cleaning useful? A review of the scientific evidence. Indoor Air 2010, 20, 445–457. [Google Scholar] [CrossRef] [PubMed]
- Söderholm, A.; Öhman, A.; Stenberg, B.; Nordin, S. Experience of living with nonspecific building-related symptoms. Scand. J. Psychol. 2016, 57, 406–412. [Google Scholar] [CrossRef] [PubMed]
- Vuokko, A.; Selinheimo, S.; Sainio, M.; Suojalehto, H.; Järnefelt, H.; Virtanen, M.; Kallio, E.; Hublin, C.; Karvala, K. Decreased work ability associated to indoor air problems—An intervention (RCT) to promote health behavior. Neurotoxicology 2015, 49, 59–67. [Google Scholar] [CrossRef] [PubMed]
- Fuertes, E.; Standl, M.; Cyrys, J.; Berdel, D.; von Berg, A.; Bauer, C.-P.; Krämer, U.; Sugiri, D.; Lehmann, I.; Koletzko, S.; et al. A longitudinal analysis of associations between traffic-related air pollution with asthma, allergies and sensitization in the GINIplus and LISAplus birth cohorts. PeerJ 2013, 1, e193. [Google Scholar] [CrossRef] [PubMed]

| CRB (Control) | Calder (Experimental) | p-Value | |
|---|---|---|---|
| Demographics | |||
| Age, mean (SD) | 35.7 (13.1) | 31.2 (14.0) | 0.02 |
| Female, % (n) | 54.8% (57) | 59.8% (52) | 0.05 |
| Comorbidities | |||
| LASIK, % (n) | 13.2% (14) | 21.6% (19) | 0.12 |
| Eye allergy, % (n) | 18.7% (20) | 26.5% (15) | 0.69 |
| Current contact lens use, % (n) | 17.9% (19) | 22.7% (20) | 0.53 |
| Active smoker, % (n) | 8.6% (9) | 10.2% (9) | 0.46 |
| Eczema, % (n) | 3.7% (4) | 4.4% (4) | 0.82 |
| Building | |||
| Hours in building, mean (SD) | 3.4 (2.9) | 2.3 (2.2) | 0.005 |
| Home environment | |||
| Subjects living in home built before 1980, % (n) | 20.2% (19) | 19.1% (14) | 0.87 |
| Carpets at home, % (n) | 39.4% (41) | 40% (34) | 0.94 |
| Variable, Mean (CI) | Calder | CRB | Difference |
|---|---|---|---|
| Number of particles ≥ 0.5 µm/feet3 | 24,436 (23,338–25,533; 45) | 12,213 (11623.30–12802.92; 45) | 12,223 |
| Number of particles ≥ 5 µm/feet3 | 1372 (1231–1512; 45) | 799 (683.19–914.14; 45) | 573 |
| Relative humidity (%) | 62.00 (61.71–62.29; 45) | 59.54 (59.23–59.84; 45) | 2.46 |
| CO(Carbon monoxide (ppm)) | 12.87 (11.18–14.55; 122) | 11.41 (10.22–12.61; 88) | 1.45 |
| NO2 (Nitrogen dioxide (ppm)) | 7.70 (6.68–8.73; 122) | 12.85 (12.18–13.53; 88) | −5.15 |
| Temperature | 19.03 (18.70–19.37; 122) | 20.81 (20.50–21.12; 88) | −1.78 |
| Number of airborne microbial colonies/m3 | 1066 | 400 | 666 |
| Selected Variables | Presence of DE Symptoms (1 = Yes; 0 = No) OR (95% CI, p-Value) | Worsening of DE Symptoms (1 = Yes; 0 = No) OR (95% CI, p-Value) |
|---|---|---|
| Building Location | ||
| CRB (reference) | 1 | 1 |
| Calder | 1.51 (0.82–2.78; 0.19) | 2.21 (1.06–4.60; 0.03) |
| Time Spent Inside the Building (hours) | ||
| <1 h (reference) | 1 | 1 |
| 1 to 3 h | 0.54 (0.26–1.14; 0.10) | 0.72 (0.30–1.72; 0.45) |
| >3 h | 0.34 (0.15–0.76; 0.01) | 0.45 (0.18–1.16; 0.09) |
| Contact Lens Wear | ||
| No (reference) | 1 | 1 |
| Not wearing now | 0.48 (0.13–1.81; 0.27) | 1.83 (0.58–5.84; 0.29) |
| Yes | 1.53 (0.73–3.21; 0.25) | 2.20 (0.94–5.13; 0.06) |
| Smoking | ||
| No (reference) | 1 | 1 |
| Inactive (smoked in the past) | 0.76 (0.29–1.95; 0.57) | 0.43 (0.12–1.56; 0.19) |
| Yes | 0.45 (0.12–1.68; 0.22) | 0.72 (0.19–2.72; 0.63) |
| LASIK Surgery | ||
| No (reference) | 1 | 1 |
| Yes | 4.39 (1.96–9.78; <0.001) | 5.67 (2.26–14.25; <0.001) |
| Self-reported Eye Allergies | ||
| No (reference) | 1 | 1 |
| Yes | 6.84 (2.75–17.00; 0.00) | 4.37(1.80–10.61; 0.00) |
| Eczema | ||
| No (reference) | 1 | 1 |
| Yes | 1.28 (0.29–5.55; 0.74) | 1.30 (0.24–7.02; 0.76) |
| Home Construction Year | ||
| Before 1980 (reference) | 1 | 1 |
| In or after 1980 | 0.86 (0.39–1.91; 0.69) | 1.45 (0.53–3.90; 0.32) |
| Temperature Indoor (°F) | ||
| <70 °F (<21 °C) (reference) | 1 | 1 |
| 70–75 °F (21–23 °C) | 1.15 (0.57–2.33; 0.69) | 1.14 (0.52–2.53; 0.75) |
| >75 °F (>23 °C) | 0.22 (0.06–0.90; 0.02) | 0.12 (0.01–1.05; 0.02) |
| Carpet in the House | ||
| No (reference) | 1 | 1 |
| Yes | 1.84 (0.98–3.46; 0.05) | 1.98 (0.95–4.16; 0.06) |
| Variables | Dry Eye Symptoms at Present (0 = No; 1 = Yes) | |||||
|---|---|---|---|---|---|---|
| Building (0 = CRB, 1 = Calder Library) | 1.51 | 3.81 ** | 4.01 ** | 3.89 * | ||
| (0.82–2.78) | (1.42–10.23) | (1.40–11.48) | (1.21–12.50) | |||
| Time Spent Inside the Building (hours) | 0.92 | 0.44 * | 0.43 * | 0.51 * | ||
| (0.80–1.05) | (0.22–0.86) | (0.20–0.90) | (0.27–0.97) | |||
| Building × Time Spent in the Building (hours) | 1 | 1.007 * | 1.007 * | 1.01 * | ||
| (0.1–1.00) | (1.001–1.013) | (1.001–1.014) | (1.00–1.01) | |||
| Eye Allergy Status (0 = no, 1 = yes) | 5.97 ** | 10.03 ** | ||||
| (2.41–14.79) | (3.13–32.18) | |||||
| Eczema Status (0 = no, 0 = yes) | 0.92 | |||||
| (0.14–6.25) | ||||||
| Age (years) | 1.01 | |||||
| (0.98–1.05) | ||||||
| Sex (0 = female, 1 = male) | 0.76 | |||||
| (0.34–1.70) | ||||||
| LASIK Surgery (0 = no, 1 = yes) | 3.74 ** | |||||
| (1.41–9.92) | ||||||
| Contact Lens Wear (0 = no; 1 = not now, 2 = yes) | 0.9 | |||||
| (0.53–1.54) | ||||||
| Smoking Status (0 = no; 1 = previous; 2 = yes) | 0.32 * | |||||
| (0.11–0.87) | ||||||
| Home Construction Year (0 = before 1980; 1 = 1980 and after) | 1.07 | |||||
| (0.34–3.35) | ||||||
| Temperature Indoor (°F) | 0.92 | |||||
| (0.81–1.03) | ||||||
| Carpet in the House (0 = no, 1 = yes) | 1.58 | |||||
| (0.70–3.57) | ||||||
| Observations | 190 | 195 | 187 | 187 | 187 | 169 |
| Variables | Worsening of DE Symptoms = 1, Otherwise = 0 Odds Ratio (95% Confidence Interval) | |||||
|---|---|---|---|---|---|---|
| Building (0 = CRB, 1 = Calder Library) | 2.21 ** | 6.95 *** | 6.97 *** | 13.30 *** | ||
| (1.08–4.55) | (2.09–23.04) | (2.03–23.91) | (2.80–63.31) | |||
| Time Spent Inside the Building (hours) | 0.95 | 0.45 *** | 0.45 *** | 0.41 ** | ||
| (0.82–1.10) | (0.26–0.78) | (0.25–0.79) | (0.19–0.92) | |||
| Building × Time Spent in the Building (hours) | 1 | 1.01 *** | 1.01 *** | 1.01 ** | ||
| (0.1–1.00) | (1.00–1.01) | (1.00–1.01) | (1.00–1.02) | |||
| Eye Allergy Status (0 = no, 1 = yes) | 3.35 ** | 4.05 ** | ||||
| (1.31–8.57) | (1.18–13.92) | |||||
| Eczema Status (0 = no, 0 = yes) | 2.33 | |||||
| (0.28–19.35) | ||||||
| Age (years) | 0.99 | |||||
| (0.94–1.04) | ||||||
| Sex (0 = female, 1 = male) | 1.19 | |||||
| (0.44–3.23) | ||||||
| LASIK Surgery (0 = no, 1 = yes) | 9.74*** | |||||
| (2.91–32.58) | ||||||
| Contact Lens Wear (0 = no; 1 = not now, 2 = yes) | 1.70 * | |||||
| (0.92–3.11) | ||||||
| Smoking Status (0 = no; 1 = previous; 2 = yes) | 0.27 * | |||||
| (0.07–1.02) | ||||||
| Home Construction Year (0 = before 1980; 1 = 1980 and after) | 1.2 | |||||
| (0.30–4.80) | ||||||
| Temperature Indoor (°F) | 0.88 | |||||
| (0.75–1.03) | ||||||
| Carpet in the House (0 = no, 1 = yes) | 1.73 | |||||
| (0.66–4.56) | ||||||
| Observations | 169 | 169 | 166 | 166 | 166 | 152 |
© 2020 by the authors. Licensee MDPI, Basel, Switzerland. This article is an open access article distributed under the terms and conditions of the Creative Commons Attribution (CC BY) license (http://creativecommons.org/licenses/by/4.0/).
Share and Cite
Idarraga, M.A.; Guerrero, J.S.; Mosle, S.G.; Miralles, F.; Galor, A.; Kumar, N. Relationships Between Short-Term Exposure to an Indoor Environment and Dry Eye (DE) Symptoms. J. Clin. Med. 2020, 9, 1316. https://doi.org/10.3390/jcm9051316
Idarraga MA, Guerrero JS, Mosle SG, Miralles F, Galor A, Kumar N. Relationships Between Short-Term Exposure to an Indoor Environment and Dry Eye (DE) Symptoms. Journal of Clinical Medicine. 2020; 9(5):1316. https://doi.org/10.3390/jcm9051316
Chicago/Turabian StyleIdarraga, Maria A., Juan S. Guerrero, Samantha G. Mosle, Frank Miralles, Anat Galor, and Naresh Kumar. 2020. "Relationships Between Short-Term Exposure to an Indoor Environment and Dry Eye (DE) Symptoms" Journal of Clinical Medicine 9, no. 5: 1316. https://doi.org/10.3390/jcm9051316
APA StyleIdarraga, M. A., Guerrero, J. S., Mosle, S. G., Miralles, F., Galor, A., & Kumar, N. (2020). Relationships Between Short-Term Exposure to an Indoor Environment and Dry Eye (DE) Symptoms. Journal of Clinical Medicine, 9(5), 1316. https://doi.org/10.3390/jcm9051316

